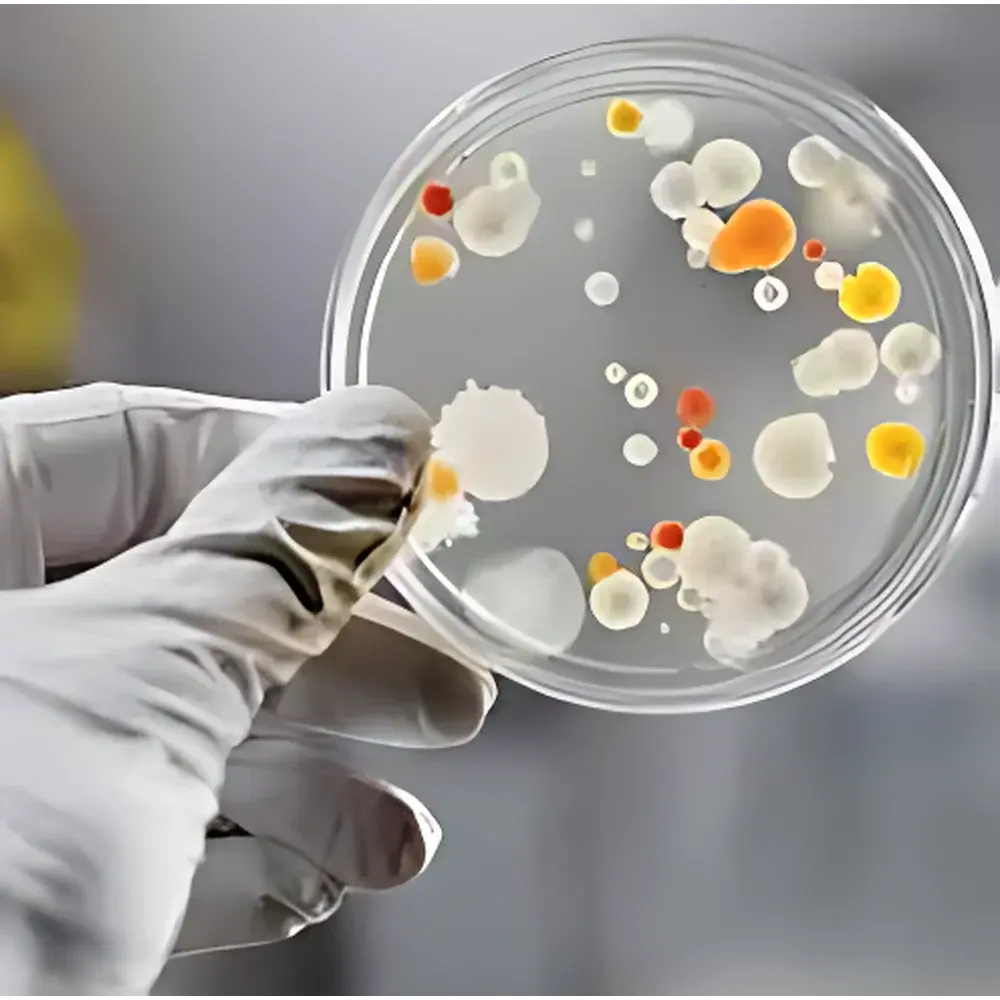
PixelCam™ Series Multispectral Camera

PixelCam™ Series Multispectral Camera
| Origin | UK |
|---|---|
| Manufacturer Type | Distributor |
| Origin Category | Imported |
| Model | PixelCam™ |
| Pricing | Upon Request |
Overview
The PixelCam™ Series Multispectral Camera is a wafer-level integrated, OEM-optimized imaging platform engineered for high-fidelity spectral data acquisition across the visible (400–700 nm), near-infrared (NIR: 700–1000 nm), and short-wave infrared (SWIR: 1000–2500 nm) ranges. Unlike sequential or scanning multispectral systems, PixelCam™ employs a monolithic, pixel-level dichroic filter mosaic fabricated directly onto the sensor die—enabling true simultaneous capture of 3 to 9 discrete spectral bands at full video frame rates (up to 33 fps). This architecture eliminates temporal misregistration, spatial parallax, and inter-band latency—critical constraints in dynamic applications such as UAV-based remote sensing, real-time industrial inspection, and clinical tissue assessment. The system operates on standard CMOS/CCD imaging principles but extends functionality through spectral multiplexing at the pixel level, delivering per-pixel spectral signatures without sacrificing spatial resolution, form factor, power envelope, or thermal stability.
Key Features
- Wafer-level dichroic filter array integration—ensures mechanical and thermal co-registration of all spectral channels
- Simultaneous multi-band acquisition (3–9 user-specified bands) with no moving parts or tunable elements
- Video-rate operation up to 33 fps at native sensor resolution (configurable per OEM requirement)
- Compact, low-power design compatible with handheld, drone-mounted, and embedded vision platforms
- OEM-flexible architecture: customizable spectral band selection, pixel mosaic pattern (e.g., Bayer-like or optimized sparse layouts), sensor type (global shutter CMOS or interline CCD), and mechanical housing
- Robust calibration framework supporting radiometric and spectral response correction across operating temperature range (−10°C to +60°C)
Sample Compatibility & Compliance
PixelCam™ modules are designed for integration into regulated and non-regulated environments alike. For medical imaging applications, the optical path meets ISO 13485-aligned manufacturing controls; spectral response traceability is supported via NIST-traceable reference sources. In agricultural and environmental monitoring, the system complies with ASTM E2721 (Standard Practice for Multispectral Imaging of Vegetation) and supports NDVI, NDRE, and other vegetation index calculations directly from raw band data. All electronic subsystems conform to CE, FCC Part 15 Class B, and RoHS directives. Optional firmware versions include audit-ready metadata logging (timestamp, exposure, gain, temperature) compliant with GLP/GMP documentation requirements.
Software & Data Management
The PixelCam™ SDK provides cross-platform C/C++, Python, and MATLAB APIs for low-level sensor control, real-time streaming, and batch post-processing. Raw data is output in 12-bit or 16-bit linear format with embedded spectral metadata (wavelength center, FWHM, quantum efficiency curve). The included SpectraView™ desktop application enables interactive band combination, false-color mapping, spectral library matching (using Euclidean or spectral angle mapper algorithms), and export to ENVI, HDF5, or GeoTIFF formats with georeferencing support. For production deployment, the SDK supports deterministic frame synchronization via hardware trigger inputs and GenICam-compliant interface definitions—facilitating seamless integration into existing machine vision frameworks (e.g., HALCON, OpenCV, or NI Vision).
Applications
- Agricultural phenotyping: Real-time crop health assessment via chlorophyll, water stress, and nitrogen content indices
- Medical diagnostics: Non-invasive tissue oxygenation mapping and lesion differentiation in dermatology and ophthalmology
- Industrial quality control: Detection of material composition variance, coating thickness uniformity, and counterfeit product identification
- UAV-based remote sensing: High-resolution multispectral surveying for precision forestry, mineral prospecting, and floodplain analysis
- Water quality monitoring: Quantification of chlorophyll-a, suspended solids, and colored dissolved organic matter (CDOM) in inland and coastal waters
- Security & authentication: Spectral signature verification of documents, banknotes, and pharmaceutical packaging
FAQ
Can PixelCam™ be calibrated for specific spectral bands outside the standard VIS-NIR-SWIR range?
Yes—custom dichroic filter mosaics can be fabricated for wavelengths between 350 nm and 2500 nm, subject to sensor quantum efficiency and optical transmission constraints.
Is radiometric calibration provided with each unit?
Each module ships with factory-applied radiometric coefficients and a certificate of spectral responsivity traceable to NIST standards; field recalibration kits are available upon request.
What interface protocols are supported?
Standard interfaces include USB3 Vision, GigE Vision, and MIPI CSI-2; custom FPGA-based LVDS or SLVS-EC implementations are supported for embedded OEM integration.
How is synchronization handled across multiple PixelCam™ units in a stereo or array configuration?
Hardware trigger input/output pins support sub-microsecond inter-camera sync; optional PTP (IEEE 1588) time-stamping is available for distributed multi-node deployments.
Does the system support FDA 21 CFR Part 11 compliance for regulated medical use?
Firmware and software packages with electronic signature, audit trail, and role-based access control are available under validated configuration for Class II medical device applications.